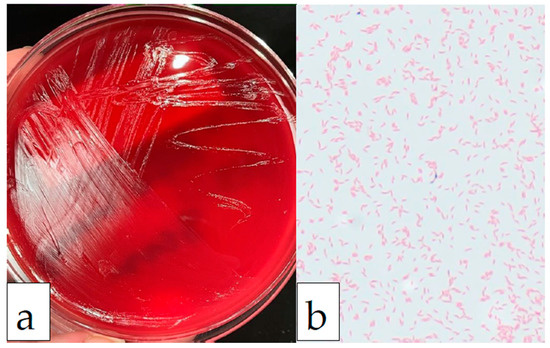
Infectious Disease Reports Free FullText Mobiluncus curtisii

Mobiluncus es un género de bacterias gram-variables,[1] anaeróbicas. Se trata de bacilos curvos flagelados. Sus especies se encuentran en la vagina, particularmente asociada con Gardnerella vaginalis en casos de vaginosis bacteriana.
Especies
- Mobiluncus curtisii
- Mobiluncus holmesii
- Mobiluncus mulieris
- Mobiluncus porci
Referencias